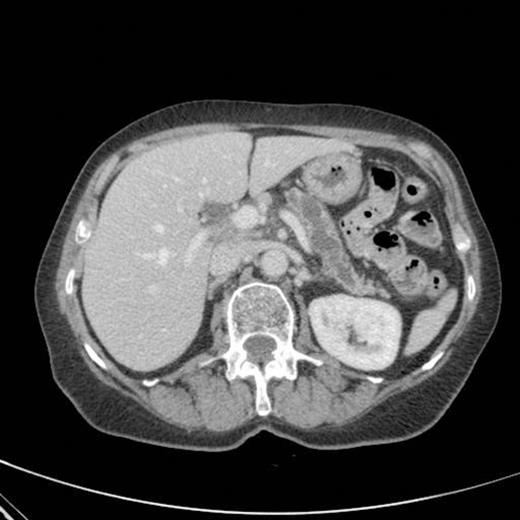
CT scan showing marked dilatation and tortuosity of the main pancreatic duct (12-13mm at the head) with atrophy of the body and tail
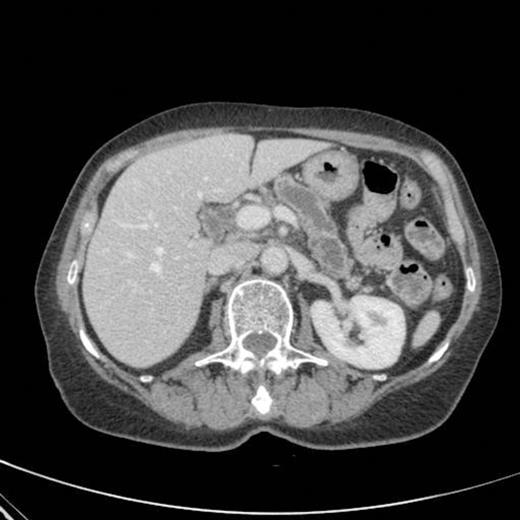
CT scan showing pancreatic duct dilatation to 15 mm with side branch dilatation in uncinate process and atrophic pancreas
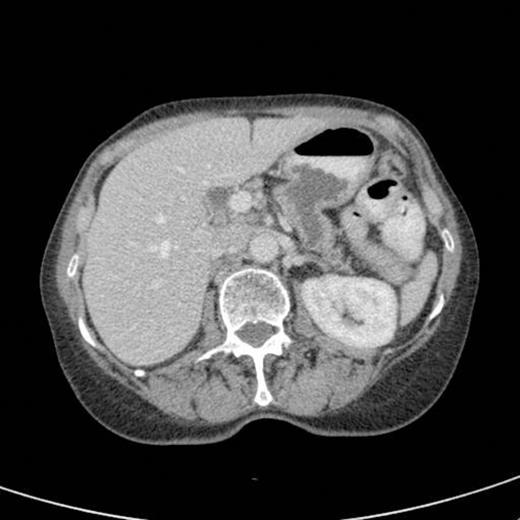
CT scan showing persistent gastro pancreatic fistula

-
PDF
- Split View
-
Views
-
Cite
Cite
V Rao, R Sarkar, A Smithies, A Razack, K Wedgwood, Spontaneous gastro-pancreatic fistula – a hitherto unknown natural history of IPMN?, Journal of Surgical Case Reports, Volume 2012, Issue 6, June 2012, Page 9, https://doi.org/10.1093/jscr/2012.6.9
Close - Share Icon Share
Abstract
Intraductal papillary mucinous neoplasm (IPMN) is a distinct group of benign pancreatic neoplasms often discovered incidentally on imaging. Apart from their malignant potential, little is known about their natural history as most are surgically resected. We report an unusual presentation and possible natural history of IPMN in a patient who refused surgery and hence was on regular follow up.
INTRODUCTION
Intraductal papillary mucinous neoplasm (IPMN), first reported in 1982 as “mucin-producing tumor” by Kazuhiko Ohashi of Japanese Foundation for Cancer Research, is a well recognised category of pancreatic neoplasms characterised by intraductal, often papillary proliferation of neoplastic mucinous cells, which produce thick mucinous secretion leading to cystic dilatation of the pancreatic ducts (1,2). We report an interesting case where an IPMN progressed to a spontaneous gastropancreatic fistula over a period of 10 years as the patient declined surgery at the time of initial diagnosis.
CASE REPORT
A 64-year-old female presented with history of intermittent episodes of upper abdominal pain aggravated by fatty foods lasting for about half an hour. This was not associated with nausea, vomiting or weight loss. Apart from thyrotoxicosis for which she was on carbimazole, she did not have any significant medical history. Abdominal ultrasound revealed dilated pancreatic duct and gall stones and this was confirmed on CT scan with no demonstrable pancreatic lesion. Upper GI endoscopy was unremarkable. A percutaneous pancreaticogram was done which revealed a round filling defect of 15 mm occupying the main pancreatic duct in the region of the head of pancreas raising the possibility of a mucinous ductal neoplasm. A further filling defect was seen within the main pancreatic duct at the junction of the body and tail which was thought to be a mucous plug. A diagnosis of mucinous ductal epitheliosis of the pancreas was considered and she was offered surgery as this was a premalignant condition. This was declined by the patient and hence a decision was made to place her on surveillance with regular CT scans to monitor progress of the lesion.
CT scan showing marked dilatation and tortuosity of the main pancreatic duct (12-13mm at the head) with atrophy of the body and tail
CT scan showing pancreatic duct dilatation to 15 mm with side branch dilatation in uncinate process and atrophic pancreas
CT scan done 2 years later revealed marked dilatation and tortuosity of the main pancreatic duct (12-13mm at the head) with atrophy of the body and tail (Fig1). Repeat scans done on an yearly basis over the next three years reported no progressive change. CT scan done 6 years after the original diagnosis revealed pancreatic duct dilatation to 15 mm with side branch dilatation in uncinate process and atrophic pancreas (Fig 2). A diagnosis of mucinous ductal ectasia or an intraductal papillary mucinous tumour was suggested. On clinical review, patient complained of epigastric discomfort, loose stools, anorexia and weight loss. Upper GI endoscopy and colonoscopy was normal. Faecal elastase was less than 100 confirming pancreatic insufficiency for which she was commenced on creon.

CT scan done at 10 years after initial diagnosis as part of routine surveillance revealed gross dilatation of main pancreatic duct to 10 mm along with a widely patent communication between the pancreatic duct and the stomach raising the possibility of a spontaneous gastro-pancreatic fistula measuring up to 19 mm associated with layering of mucin within the stomach. (Fig 3). The pancreas did not reveal any mass lesion and was globally atrophic. An upper GI endsocopy was done and this revealed a little crater with mucus plug in the body of the stomach along the lesser curve representing the opening of the gastropancreatic fistula. Biopsies taken around the fistula revealed non-specific inflammation. On clinic review, the patient complained of increased frequency of bowel habits, which was thought to be due to intestinal hurry caused by the fistula. This responded well to increased dose of creon.
A subsequent CT scan done a year later confirmed the persistence of the gastro pancreatic fistula with polypoid herniation into the stomach and this was thought to represent main duct IPMN with mucinous tumour herniation into stomach (Fig 4). An upper GI endoscopy confirmed the gastric opening of the fistula at 50 cm on the lesser curve with a mucus plug sealing the opening (Fig 5). Biopsies were taken from around the fistulous opening and this was reported as non-specific inflammation. Again, a surgical option was offered that was declined by the patient and hence it was decided to continue with regular follow up and conservative management.

DISCUSSION
IPMN have been reported to account for approximately 7% of clinically diagnosed pancreatic neoplasms and up to 50% of incidentally detected pancreatic cysts (3). Patients with IPMN are usually elderly with a slight male predominance. About a third of patients are symptomatic and may present with non specific symptoms which manifest as recurrent pancreatitis, steatorrhoea, diabetes and weight loss. In most cases, IPMNs are discovered incidentally during imaging performed for a different indication and appear as a dilated pancreatic duct full of mucin, which extrudes out of a bulging papilla (4).
Architecturally, IPMNs have a spectrum of cyst and papilla formation ranging from predominantly cystic or exclusively papillary. Larger, more complex lesions or those with abundant papilla formation (mural nodules) are more likely to harbour carcinoma 1. On the basis of the location, IPMNs are classified into three types: the branch duct type (small tumours, commonly adenomas, relatively low incidence of carcinoma); the main duct type (more proliferative, larger, complex tumours with atypia); and the mixed type, which includes features of both the above types (4). Pathologically, main duct type proliferation has substantial potential for progression into aggressive invasive carcinoma.
Apart from possibility of malignant transformation (risk of malignancy is approximately 70% in main branch IPMN (5)), there is little information regarding natural history of IPMN in the literature, as most IPMNs are resected in view of their malignant potential. The only other reported case of a gastropancreatic fistula caused by IPMN is in a 83-year old Japanese man who presented with a one week history of malaena. Upper GI endoscopy revealed a villous tumour associated with mucous discharge in the posterior wall of the gastric body. Biopsies revealed mucin-producing epithelium with nuclear atypia. CT scan demonstrated communication between the dilated main pancreatic duct and the gastric lumen (6). In this case, the evolution of gastropancreatic fistula occurred over a period of ten years and this was because the patient declined surgery at the time of the initial diagnosis. We suggest that formation of spontaneous gastro pancreatic fistula may be one of the less known sequelae of unresected IPMN in the small minority of patients who do not develop malignant transformation.